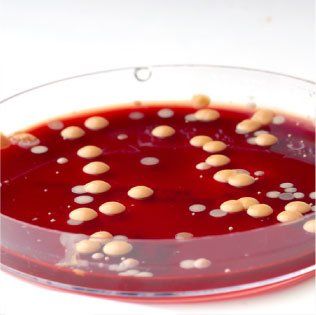
Un gros plan d'une boîte de Petri remplie de liquide rouge

Analyse d'eau
Analyse d'eau
Analyse bactériologique et physico-chimique
Les paramètres de l’eau peuvent varier selon les éléments contenus dans le sol. C’est pourquoi, il est fortement recommandé de réaliser une analyse d'eau de votre puits au moins une fois par an, afin de vous certifier qu'elle est potable et d'évaluer si elle a changé au niveau physico-chimique.
Maison neuve ou achat d’une nouvelle maison
Au moment d'acheter une maison existante ou une maison en construction, il est fort probable que l'institution financière avec qui vous négociez l'hypothèque exigera une analyse bactériologique afin de s'assurer que l'eau provenant de votre puits est potable. L'analyse bactériologique offerte par Les Pompes Garand est reconnue par les institutions financières, les firmes de courtage immobilier et les notaires.
Une eau saine est un élément indispensable pour être en bonne santé. Ne prenez donc aucun risque, faites analyser votre eau une fois par année tel que recommandé par Santé Canada. De plus, si vous remarquez un changement majeur de votre eau, il est important de faire vérifier votre eau par un de nos spécialistes. L'analyse d'eau "potable" détermine s'il y a des bactéries nuisibles à la santé et l'analyse "bactériologique" doit être effectuée par un laboratoire accrédité par le Ministère de l'Environnement.
L'analyse de la physico-chimie de l'eau détermine si celle-ci contient des éléments non-bactériologiques, mais problématique pour vos appareils et votre santé. Les principaux éléments analysés sont : la dureté, le fer, le ph, les TDS, le soufre, le tannin et le manganèse. On peut retrouver plus d’une centaine d’éléments qui peuvent être analysés. Consultez un de nos spécialistes pour plus de détails.
Formulaire analyse d'eau
Afin que nous puissions répondre à votre entière satisfaction dans les meilleurs délais, veuillez compléter cette section en remplissant toutes les cases appropriées.